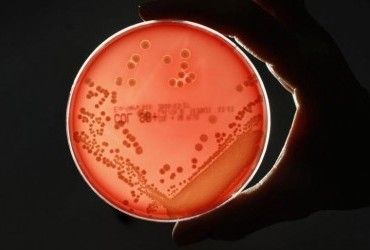
Бактерії стали більш стійкими до антисептиків на основі спирту - вчені

У 40-річної жінки з Каліфорнії розвинулася бактеріальна інфекція після приготування риби, яку вона нібито купила на ринку в Сан-Хосе. Лікарям довелося ампутувати їй всі кінцівки.
Експерти кажуть, що тип інфекції, яка спричинила її хворобу, може стати більш поширеним із погіршенням кліматичних змін. Про це пише Independent.
Згідно зі сторінкою GoFundMe, організованою подругою сім’ї Анною Мессіною, Лаура Барахас приготувала та з’їла рибу, а потім була госпіталізована більше ніж на місяць. Потім, 13 вересня, лікарям довелося видалити обидві руки та ноги, щоб врятувати її життя.
Згідно з повідомленнями WHNT News 19, Барахас купила і з'їла рибу тіляпію, після чого в неї почалися симптоми Vibrio vulnificus.
За даними Центру контролю та профілактики захворювань США (CDC), у людей може розвинутися вібріонна інфекція після споживання сирих чи недостатньо оброблених морепродуктів чи устриць, або через відкриту рану.
1 вересня CDC опублікувало рекомендації щодо охорони здоров’я, попереджаючи громадськість про інфекції Vibrio, які пов’язані з теплими прибережними водами. Дослідження, опубліковане в березні в журналі Scientific Reports, показало, що через глобальне потепління найближчими роками ми можемо спостерігати зростання випадків цієї смертельної інфекції.
Інфекції Vibrio vulnificus зазвичай смертельні: близько 20 відсотків людей, у яких вони розвиваються, помирають, іноді протягом двох днів після захворювання. Пацієнти з інфекцією іноді потребують інтенсивної терапії та ампутації. На додаток до ампутації, їм може також знадобитися видалення мертвих тканин.
Інфекції Vibrio можуть викликати такі виснажливі симптоми, як спазми в шлунку, водяниста діарея, нудота, лихоманка, блювота, озноб, низький кров'яний тиск і утворення пухирів на шкірі. Якщо рана була інфікована цими бактеріями, симптоми можуть також включати почервоніння, набряк, біль, тепло, зміну кольору та виділення.
Інфекцію можна діагностувати, якщо бактерії Vibrio виявлені у зразку крові чи калу хворої людини або якщо вони знайдені в рані пацієнта.
Щоб уникнути контакту з бактеріями Vibrio, CDC рекомендує мити руки водою з милом після роботи з сирими молюсками та приготування устриць та інших молюсків перед їх вживанням.
Устриці потрібно варити не менше трьох хвилин; смажити в олії принаймні три хвилини при 190 градусах за Цельсієм; смажити в 7,5 см від джерела тепла протягом трьох хвилин; або випікати при температурі 205 градусів протягом 10 хвилин. Молюсків слід варити до тих пір, поки раковини не розкриються, потім кип'ятити ще три-п’ять хвилин або помістити в пароварку (після того, як вода вже закипить) і варити ще чотири-дев’ять хвилин, рекомендують у CDC.
Незважаючи на те, що інфекція Vibrio може вразити будь-кого, певні люди мають більшу ймовірність розвитку важких ускладнень, попереджають у CDC. Серед них люди:
- із захворюваннями печінки, раком, ВІЛ, діабетом або таласемією;
- які приймають ліки, через які організму важче боротися з мікробами;
- які приймають ліки для зниження кислотності шлунка;
- які нещодавно перенесли операцію на шлунку.
Якщо ви належите до групи високого ризику, ви можете зменшити свої шанси заразитися, не заходячи до води, якщо у вас відкрита рана; і ретельно очищаючи рани, якщо вони контактували з сирими морепродуктами, морською водою або солонуватою водою.
Інші дослідження інфекцій Vibrio
Як повідомляв УНІАН, кілька років тому група вчених із Італії та США досліджувала зв'язок бактерій роду вібріони (Vibrio) з температурою морської води, а також їхній вплив на рівень смертності людей. Вони знайшли кореляцію між вмістом у планктоні бактерій з підвищенням температури води (на 1,5 °C за останні 54 роки).
Рід Vibrio включає понад 40 видів; практично всі вони призводять до гастроентеритів і нерідко - до холери. Людина, інфікована бактерією V. Vulnificus, також може отримати такі ускладнення, як сепсис, гострий уретрит і прострий кардіоваскуліт, а наслідками зараження V. cincinnatiensis стають менінгіт або енцефаліт.
З 2009 року лише в США до лікарень щороку потрапляє близько 300 осіб, із них 40 помирає через наслідки зараження вібріонами. За даними за 2014 рік, 7 з 10 пацієнтів, що потрапили до лікарні з таким діагнозом, захворіли після вживання молюсків.